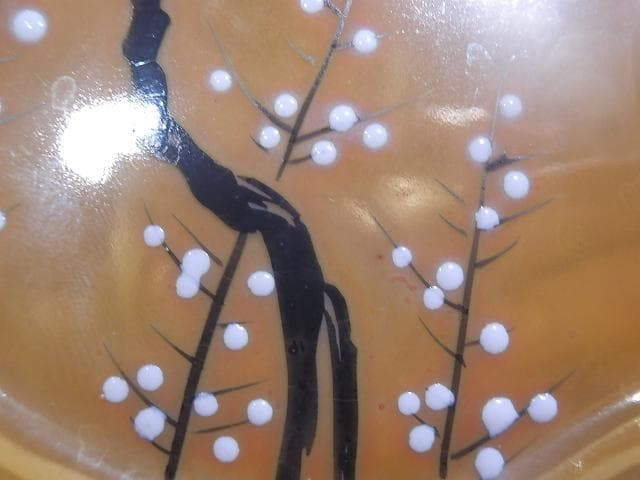
サーブプレート　ラスター　オールドニッポン　梅に鶯ではなく何鳥？

サーブプレート ラスター オールドニッポン 梅に鶯ではなく何鳥?
(3684件)
Pontaパス特典
サンキュー配送
6570円(税込)
66ポイント(1%)
Pontaパス会員ならさらに+1%ポイント還元!
送料
(
)
4
配送情報
お届け予定日:2026.05.18 6:54までにお届け
※一部地域・離島につきましては、表示のお届け予定日期間内にお届けできない場合があります。
ロットナンバー
70975173600
お買い物の前にチェック!

Pontaパス会員なら
ポイント+1%
ポイント+1%
商品説明
18.7cmX15.8cm鶯にしたかったのだろうが うぐいす色では華がないため紅色を持ちいたのだと思う 海外用なのでそこのところお許しくださいお店の情報
7,367
連絡・応対
4.3
配送スピード
4.3
梱包
4.3